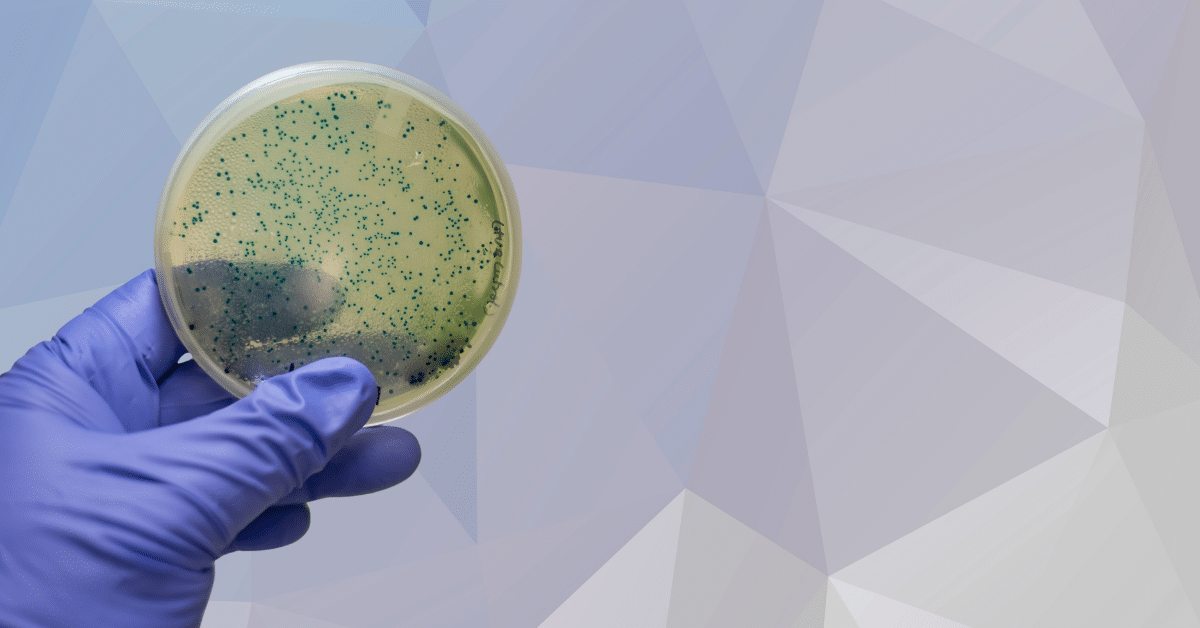

The first kitchen I worked in had one “mystery towel” that showed up every rush. You’d spot it draped over someone’s shoulder, then on a cutting board, then used to wipe a counter, then used again to grab a hot pan. Nobody meant harm, but that towel traveled like a rumor in a small town, touching everything and leaving invisible fingerprints behind.
Cross-contamination works the same way. It rarely arrives with drama. It slips in through routine shortcuts, crowded workspaces, and tools that bounce between tasks. And once it happens, you can’t rewind the day. You can only deal with the fallout: a sick customer, a failed inspection, a thrown-out batch, or a worried team.
What Cross-Contamination Really Means At Work
Cross-contamination is the spread of harmful microbes, allergens, or chemicals from one surface, food, tool, or person to another. In food settings, it often starts with raw proteins, dirty hands, shared utensils, or drip-prone storage. In other workplaces, it can show up as shared gloves in a lab, uncleaned tools in a salon, or mixed-use rags in a breakroom.
The tricky part is that it’s usually invisible. Germs don’t announce themselves. Allergens can be transferred in a dusting of flour. Chemical residues can linger on a countertop long after the smell fades. If you treat cross-contamination like glitter, you’ll get the idea: once it spreads, it turns up in places you didn’t expect.
Cross-contamination commonly happens in three ways:
- Food-to-food: raw items touching ready-to-eat foods (directly or through drips).
- Tool-to-food: knives, boards, tongs, slicers, thermometers, towels, gloves.
- Person-to-anything: hands, sleeves, aprons, phones, door handles, sanitizer bottles.
The Real-World Cost Of “Just This Once”
When cross-contamination leads to foodborne illness, the human cost is the headline. Public health estimates commonly cited in training programs describe foodborne illness as affecting tens of millions of people each year in the U.S., with many hospitalizations and thousands of deaths.
Even when nobody gets sick, businesses still pay. One contaminated prep table can trigger:
- product loss from discarding ingredients and prepared items
- downtime while the team re-cleans and resets stations
- customer trust issues when complaints or reviews surface
- inspection pressure and corrective actions
- staff stress when blame starts flying
That’s why prevention works best when it’s designed into the workflow, not “remembered” during the rush.
How Can Cross-Contamination Be Avoided at Work?
Start by building a system that makes the safe choice the easy choice. People follow what the workspace “nudges” them to do. If the raw chicken station is next to the salad station, you’re asking for trouble. If clean tools are stored far away and dirty tools pile up close by, the pile wins.
Use this prevention stack as your foundation:
- Separate tasks by zone (raw, ready-to-eat, allergen-sensitive, dish/dirty).
- Control tools and surfaces (dedicated equipment, clear labeling, smart storage).
- Upgrade hand and glove habits (wash timing, glove change rules, no false confidence).
- Clean and sanitize with a plan (right products, right order, right frequency).
- Protect allergen management (especially for flour, nuts, dairy, eggs, soy, sesame).
- Train and verify (simple standards, quick refreshers, visible checks).
This isn’t about perfection. It’s about creating fewer “accident doors” that germs and allergens can walk through.
Build A Simple Zone Map That People Can Follow
Think of your workspace like a one-way street system. When traffic has lanes, you get fewer crashes. When everything is a free-for-all, chaos becomes the default.
Start with two paragraphs on what zones mean in your space. Then make it concrete with a short map your team can repeat out loud.
A practical zone setup:
- Raw Zone: handling raw meat, poultry, seafood, eggs (and their packaging).
- Ready-to-Eat Zone: salads, sandwiches, garnishes, finished plates.
- Allergen Care Zone: any prep for allergy requests or “no-contact” builds.
- Dirty Zone: dish drop, trash, mop sink, bus tubs, chemical storage.
Now add “rules of travel” between zones:
- Move from clean to dirty, not the other way around.
- Tools that enter Raw Zone do not wander into Ready-to-Eat Zone without washing and sanitizing.
- Finished food stays physically separated from prep work, even for a moment.
Two paragraphs later, repeat the idea in plain language: “Raw stays raw, ready-to-eat stays protected, and the dirty area is where mess belongs.”
Tools, Boards, And Towels: Stop The Silent Spread
A shared utensil can act like a paintbrush dipped in invisible dye. It only takes one pass to mark the next surface.
Set up controls that reduce decision-making during busy times:
- Store dedicated tools at each station (tongs, spatulas, ladles, thermometers).
- Label containers and squeeze bottles so they don’t get swapped mid-shift.
- Keep clean tools in a protected bin or rack, not on the counter “for convenience.”
Towels deserve special attention. A towel used for wiping raw spills should never be used on a ready-to-eat surface. If you use wiping cloths:
- Keep them in sanitizer solution at the right concentration for the job.
- Swap cloths often and replace solution on schedule.
- Use separate cloth systems for raw stations versus ready-to-eat stations.
If your workplace prefers disposable wipes, create a routine: wipe, discard, wash hands. Make the routine the habit, not the exception.
Handwashing And Gloves Without The False Confidence
Gloves can be helpful, but they can also become a costume that tricks people into feeling “clean.” A gloved hand that touches raw chicken and then a fridge handle spreads contamination just as fast as a bare hand.
Set clear handwashing moments that match real workflows:
- before starting work and after breaks
- after handling raw items or their packaging
- after touching trash, phones, doors, hair/face, or cleaning tools
- before switching from prep to plating or packaging
Then define glove rules that are easy to remember:
- Gloves are single-task, not all-shift.
- Change gloves when changing tasks or zones.
- Wash hands before putting on new gloves.
In practice, this becomes a rhythm: wash, glove, do the task, remove, wash, move on. That rhythm protects people even when the line is loud and fast.
Cleaning And Sanitizing That Actually Works In Real Life
Cleaning removes dirt and residue. Sanitizing reduces microbes to safer levels. If you skip cleaning and go straight to sanitizing, the sanitizer has to fight through grime, like trying to mop over mud.
A workable daily pattern:
- During prep: wipe spills right away, swap cutting boards and tools on a set timer.
- Between tasks: clean and sanitize the surface before ready-to-eat prep begins.
- After rush: reset stations, replace sanitizer buckets, remove trash, wash hands.
- Close: full breakdown of equipment, high-touch points, floors, and drains.
High-risk “touch magnets” to add to your checklist:
- cooler handles, oven knobs, faucet levers
- shared pens, clipboards, POS screens
- scoops in bins, spice lids, condiment rails
- sanitizer spray triggers and soap dispensers
If you need a simple rallying line for the team: “Clean first, sanitize second, dry where required, and keep clean tools protected.”
Storage, Labeling, And Workflow That Prevent Drips And Mix-Ups
A lot of cross-contamination happens when food is stored like luggage piled in a car trunk. Gravity wins. Drips happen. Containers get bumped. Lids don’t fit quite right.
Build storage habits that guard ready-to-eat foods:
- Store raw foods below ready-to-eat items in coolers.
- Keep raw items in sealed containers that can’t leak.
- Label and date everything so people don’t open and “check” containers repeatedly.
- Separate allergens in clearly marked, closed bins when possible.
Also look at how food moves through your space. If finished product has to pass through a raw prep area to reach the cooler, you’ve created a risk corridor. A small reroute, even just moving a shelf or changing the direction of traffic, can reduce exposure.
Allergen Cross-Contact: The Extra Layer Many Teams Miss
Allergen cross-contact is not the same as “a little flavor.” For someone with a serious allergy, a trace amount can trigger a medical emergency. The risk can come from airborne flour, shared fryer oil, reused cutting boards, or gloves touching multiple builds.
Strong allergen habits that fit busy operations:
- Dedicate a small “allergen care” kit: a clean board, knife, tongs, and a pan.
- Store allergen-free ingredients above or away from known allergens.
- Use a fresh pair of gloves and a freshly sanitized surface for every allergen order.
- Avoid shared fryer oil for allergen-sensitive items when allergens are involved.
Train staff to treat allergy requests like a priority ticket, not a nuisance. The tone matters. When leadership takes it seriously, everyone else does too.
Training Multilingual Teams Without Slowing The Operation
Most workplaces are a mix of experience levels and languages. A prevention plan has to be easy to teach and easy to repeat. Short, consistent coaching beats long lectures that people forget by next week.
If your team includes Spanish-speaking staff, pairing visual station labels with training options like food handler certification in spanish can help standardize habits and reduce misunderstandings during fast-paced shifts.
Make training stick with quick tools:
- 60-second pre-shift reminders (one topic per day)
- photo-based “this is clean, this is dirty” examples posted near stations
- buddy checks during rush: “Change gloves?” “New board?” “Sanitize first?”
The goal is shared language around safety, not perfect grammar or long meetings.
A Short Case Study: Fixing The “Mystery Towel” Problem
A café noticed recurring complaints: sandwiches tasted “off” and salads sometimes arrived with stray bits of raw onion and chicken juices on the container rim. Nobody could point to one big mistake. It was a hundred tiny ones.
They changed three things:
- Each station got its own towel system with a labeled bucket and swap schedule.
- Ready-to-eat builds were moved two feet away from raw prep, with a physical divider.
- A “tool home” rack was installed so clean tongs and knives stopped living on the counter.
Complaints dropped, waste dropped, and staff stress eased. The biggest win was psychological: the workspace stopped encouraging shortcuts. It started guiding better habits.
That’s the heart of prevention. Build the space so people don’t have to rely on memory alone.
Habits That Help Ensure Food Safety at Workplaces
How to ensure food safety at workplaces? If you want one mindset that holds up across kitchens, breakrooms, labs, and production floors, it’s this: treat clean areas like fresh snow. If you wouldn’t track mud across it, don’t bring raw-contact tools or unwashed hands across it either.
Daily habits that keep the standard steady:
- Call out zone breaks politely and immediately (“New gloves before you plate that.”)
- Keep a visible reset routine after rush periods.
- Use simple verification: checklists, thermometer logs, sanitizer checks, spot audits.
- Praise the behavior you want repeated, especially when it happens under pressure.
When safe behavior becomes normal behavior, cross-contamination stops being a constant threat and becomes a rare event that gets noticed fast.
FAQ
How Can Cross-Contamination Be Avoided at Work When It’s Busy?
Build habits that don’t require extra thinking during rush periods. Separate raw and ready-to-eat zones, keep dedicated tools at each station, and set simple “task change” rules: wash hands, change gloves, swap or sanitize tools, then start the next step. A quick post-rush reset (trash out, surfaces cleaned and sanitized, tools replaced) helps stop small messes from spreading into the next wave of orders.
What Are The Most Common Cross-Contamination Mistakes Employees Make?
The biggest ones are tool-sharing and “quick touches.” Examples include using the same tongs for raw and cooked foods, wiping counters with a multi-use towel, touching a phone and then handling food, or placing ready-to-eat items on a surface that just held raw packaging. Another frequent issue is storage: raw foods above ready-to-eat foods, leading to drips and contact that nobody notices until later.
How Often Should Surfaces And Tools Be Cleaned To Prevent Cross-Contamination?
Clean and sanitize any surface or tool when switching from raw handling to ready-to-eat work, and anytime you see spills or residue. Many teams also use timed swaps during prep, like changing boards and utensils on a set interval, because it reduces guesswork. High-touch points (handles, knobs, touchscreens) need regular attention since they can spread contamination across multiple stations quickly.
Do Gloves Prevent Cross-Contamination At Work?
Gloves help only when used with clear rules. A glove that touches raw food and then touches a fridge handle spreads contamination just like a bare hand. Gloves should be treated as single-task: change them when changing tasks or zones, and wash hands before putting on a new pair. If glove use leads to fewer handwashing moments, the workplace risk often rises instead of falling.
What’s The Best Way To Handle Allergen Requests Without Cross-Contamination?
Set up an allergen-safe routine that’s consistent every time: freshly washed hands, fresh gloves, a sanitized surface, and dedicated tools pulled from a clean kit. Keep allergen-sensitive ingredients protected from shared bins and airborne sources like flour. Communicate clearly, and treat the order as a priority ticket. The safest teams follow the same steps even when the customer “doesn’t seem that allergic,” because you can’t see risk level from the outside.